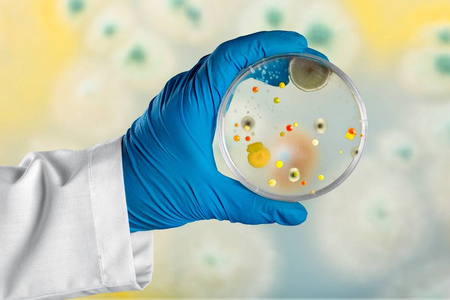
科学家的手与细菌培养皿照片

手细菌培养

试听180秒【人体26】饭前不洗手会怎样?
图片尺寸800x600
小班健康课《手上的病菌》培养幼儿良好的 - 抖音
图片尺寸1080x1906
手在手套培养皿在白色背景上.细菌
图片尺寸700x759
生动形象的讲解了手上细菌培养的过程,让同学真正感受到细菌的真实
图片尺寸1334x996
戴着手套的手拿着一个细菌培养皿
图片尺寸1200x800
戴着手套的手在培养皿中生长的细菌照片
图片尺寸450x300
微生物学家手培养培养皿白衣接种循环,在高压釜旁边
图片尺寸700x467
细菌长大了 小朋友在不洗手的情况下在细菌培养皿里按一下手指,然后
图片尺寸1054x707
戴手套手持培养皿培养细菌照片
图片尺寸200x300
【作品交流】细菌宝宝成长记_培养皿
图片尺寸1080x556
培养皿中的手的特写视图
图片尺寸1280x886
干细胞,培养,罐,移植,修理,损坏,纸巾培养实验室人员,分析,细菌,培养
图片尺寸525x350
带手套的手拿细菌在培养皿中生长照片
图片尺寸200x300
戴着手套的手,握著生长在培养皿中的 i>细 /i> i>菌 /i>
图片尺寸324x432
把脏手印在培养皿上,竟孵化出满满的细菌!
图片尺寸600x544
这是从她刚做完游戏的小手上采集的细菌,经过48小时的培养,这些细菌又
图片尺寸1066x719
洗手过后,再次用细菌培养平皿采集小朋友们的干净手印.
图片尺寸1079x1447
科学家的手与细菌培养皿照片
图片尺寸450x300
不认识的微生物学家在绿色手套拿着培养皿对着光屏幕,而工作与细菌
图片尺寸1200x800
细菌,培养皿,平衡,手指
图片尺寸233x350